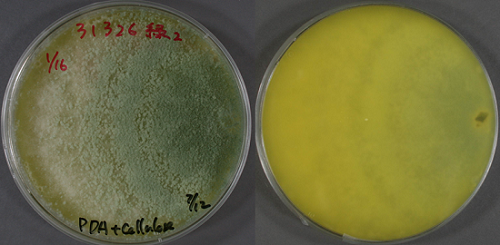
Trichoderma reesei NBRC 31326　PDAセルロース粉添加培地　培養12日目

NBRCニュース 第37号
◆◇◆ ━━━━━━━━━━━━━━━━━━━━━━━━━━━━━━━━ ◆◇◆
NBRCニュース No. 37(2016.2.1)
◆◇◆ ━━━━━━━━━━━━━━━━━━━━━━━━━━━━━━━━ ◆◇◆
NBRCニュース第37号をお届けします。新連載「あなたの活用例教えてください」を開始
しました。微生物菌株を用いた企業等の実装例について、NBRCユーザーの方々に直接その
ディープな内容を投稿していただきました。年2回程度の掲載を予定しています。最後ま
でお読みいただければ幸いです。
================================================================================
内容
================================================================================
1.新たにご利用可能となった微生物株
2.あなたの活用例教えてください(1)4種類の食中毒菌を同時培養可能な培地の評価
3.微生物あれこれ(33)セルロースを溶かすカビ、トリコデルマ(Trichoderma)
4.バイオテクノロジー産業の新たな発展に向けた政策提言について
5.NITEバイオテクノロジーセンター展示のお知らせ
================================================================================
1.新たにご利用可能となった微生物株
================================================================================
◆ NBRC株
酵母 1株、糸状菌 10株、細菌 31株、アーキア 1株が新たにご利用可能となりました。
細菌では、ポリエチレングリコール分解能のあるSphingomonas macrogoltabidus NBRC
111659およびSphingomonas terrae NBRC 111660を、アーキアでは、Methanosalsum
natronophilum NBRC 110091を公開しました。この株はアルカリ塩湖より分離された好ア
ルカリ性メタン生成古細菌で、pH 10でも旺盛に増殖することが報告されています。
【詳細】 https://www.nite.go.jp/nbrc/cultures/nbrc/new_strain/new_dna.html
◆ RD株
スクリーニング用(RD株)として果実由来の酢酸菌18株が追加になりました。是非、リ
ストをご覧ください。
【詳細】 https://www.nite.go.jp/nbrc/cultures/rd/new_rd.html
【RD株リスト】 https://www.nite.go.jp/nbrc/cultures/rd/available_rd_list.html
================================================================================
2.あなたの活用例教えてください(1)
4種類の食中毒菌を同時培養可能な培地の評価
(東洋製罐グループホールディングス株式会社綜合研究所 山崎隆明)
================================================================================
1. はじめに
東洋製罐グループホールディングス株式会社ではNBRC菌株を活用して、4種類の食中毒
菌、具体的には大腸菌、サルモネラ、黄色ブドウ球菌、腸炎ビブリオを同時検出可能なDN
Aチップ法の開発・実用化を進めています。本技術利用の有効性およびDNAチップ法の判定
精度を高めるために同時増菌培地GENOGATE broth(ジェノゲートブロス、以下GBと記載)
を用いた、4菌種の増殖能を評価しました。今回は、その内容について紹介します。
<編集局注釈>
GENOGATE(ジェノゲート)とは、食品等汚染に関与する細菌やカビの複数種が判別
可能なDNAチップ(DNAマイクロアレイ)を用いた検出・同定ツール及びサービスの総
称です。この開発・実用化検証に幅広い種類の微生物を有するNBRC菌株が活用されま
した。
【GENOGATEの紹介・お問い合わせ】 http://www.tskg-hd.com/service/dna.html
2. 食中毒菌検査に関する背景
近年消費者の「安全・安心」に関するニーズが高まっており、食品メーカーでは複数の
食中毒菌を対象とした定性検査に取り組まれております。しかし、複数の食中毒菌を培養
法で検査するには多種類の増菌培地および選択培地を作製し、判別するまでに多大な労力
とコストを要するという課題を抱えています。
3. GBの使用方法
GB 55.5 gを900 mLの精製水に溶解、1.0M水酸化ナトリウム溶液を用いてpH 7.0±0.2に
調整後、精製水を加えて1000 mLまでメスアップし、121℃で15分間滅菌します。次に食品
もしくは環境試料25 gをGB 225 mLと混和、ストマッカーで混合し、37℃、20~22時間で
培養します。
4. GBの性能評価
a) 対象4菌種を同時接種した場合の増殖能
10~100 cfuの菌濃度に調整した対象4菌種をそれぞれGBに接種し、37℃、20~22時間
で培養し、各選択培地により菌数を測定した結果、いずれの対象菌も10^5 cfu/mL以上
に同時増殖可能であることを確認しました。
b) 夾雑菌が混在した場合の増殖能
多くの食品では夾雑菌が存在していることが知られています。これらの影響を確認す
る目的で、夾雑菌と対象4菌種を同時接種した試験を行いました。夾雑菌は環境中に広
く存在するBacillus subtilis NBRC 13719を選択しました。その結果、対象4菌種は夾
雑菌が混在する場合においても各菌が10^5 cfu/mL以上に増殖することを確認しまし
た。これにより、検出に十分な菌量を確保すると共に、生死菌の判別も可能となりま
す。
c) 食品を用いた実用性検証
食品の影響を確認する目的で実用性検証を行いました。幅広い食品への適用性を確認
するため、計10種類の食品(無菌化米飯・生ハム・サーモン切り身・カット野菜・レタ
ス・トマト・ソーセージ・魚肉ソーセージ・冷凍餃子・牛乳)を選択しました。
その結果いずれの食品においても10^4 cfu/mL以上に同時増殖可能であることを確認
しました。
5. おわりに
GBおよびDNAチップ検査技術の開発・実用化検証には、対象菌株ならびに夾雑菌株を用
いた培養性能検証試験が必須となります。NBRCの菌株分譲は短納期かつ幅広い菌株の準備
があるため、短期間・低コストでの開発を可能とし、ユーザーへの新規食中毒菌検査法の
早期提案に繋げることが出来ました。
なお、GBの評価内容は第33回日本食品微生物学会学術総会にて報告を行いました。
================================================================================
3.微生物あれこれ(33)
セルロースを溶かすカビ、トリコデルマ(Trichoderma) (鶴海泰久)
================================================================================
NBRCニュース第18、19、22号の記事「バイオエタノールと微生物」のなかで、「現在利
用されている(セルロース糖化)酵素製剤のほとんどすべてはカビの仲間である
Trichoderma reeseiの特定の株によって生産されている」とお伝えしました。この生産菌
は、ソロモン諸島に駐屯した米軍キャンプのテントから分離されたQM 6a株(= NBRC 3132
6)を由来とする一連の変異株です。今回はT. reeseiを含むTrichoderma属菌について紹
介します。
Trichodermaは土壌や落葉層に常在する糸状菌で、寒天培地に接種すると2~3日で
シャーレ全面に広がるほど旺盛に生育します。シイタケ栽培菌床の有害菌として知られ、
ほかの微生物コロニーに覆い被さるだけでなく拮抗も起こすため、微生物研究者にとって
は観察や分離を邪魔する厄介者として捉えられます。一方、欧米では拮抗作用に注目し
て、植物病原菌に対する生物防除剤がいくつも開発され、積極的に使われています。
Trichodermaは子嚢菌のボタンタケ科に所属します。有性世代(統一命名法の適用以前
はHypocrea属)は倒木などの菌糸マット内に形成されますが、培養すると無性世代しか観
察されません。無性世代は菌糸がほぼ直角に分枝を繰り返し、その先端から無性胞子(分
生子)を生じます。分生子形成に伴ってコロニーは緑色を帯びますが、T. reesei NBRC
31326のように形成部位のバラツキでまだら模様を示す株もあります。Trichodermaはほか
の糸状菌と比べて分生子の形状は多様性に乏しく、形成細胞の特徴も培養条件によって不
安定なことから、種の同定が極めて困難な属として認識されてきました。1794年Persoon
による属設立の150年後には、それまでに記載されたすべての種が疑わしいと考えら
れ、1種(T. viride)に統合されました。また、RifaiはHypocreaの標本由来株を用いて
有性/無性の関係を調査し、種の識別方法が不十分と判断して9つの種集合体「species
aggregates」を提唱しました。
近年、細菌や酵母と同様に糸状菌もDNA塩基配列情報による再分類が進んできました。
Trichodermaは国際Trichoderma/Hypocrea分類小委員会(ISTH ; International Sub-
commission on Trichoderma and Hypocrea Taxonomy)の議論を経て、分類指標の選択、
基準標本および由来する培養株の確認、配列情報解析が実施されました。2005年には104
種のrRNA遺伝子ITS領域をもとにDNAバーコーディングツール「TrichOKEY」がISTHから公
開され、現在は254種2亜種が翻訳伸長因子(tef1)とRNAポリメラーゼ(rpb2)の配列情
報とともに報告されています。
NBRCでアジア各地から分離したTrichodermaを、「TrichOKEY」を用いて同定すると、
T. reeseiは熱帯から亜熱帯に分布しており、国内では沖縄に生息することが確認されま
した。日本を含めたアジアにはTrichodermaの新種と思われる株が多く見られ、T.
reesei以外にもセルロース分解活性を持つ種類が存在することから、セルロース糖化研
究において新たな知見が得られることが期待されます。
【TrichOKEY】 http://www.isth.info/tools/molkey/index.php

Trichoderma reesei NBRC 31326 PDAセルロース粉添加培地 培養12日目
左:表、右:裏 セルロース粉が消化されて透明になってきているところ
================================================================================
4.バイオテクノロジー産業の新たな発展に向けた政策提言について
================================================================================
NITEバイオテクノロジーセンターは平成27年度、健康・医療、物質生産、地方創生、基
盤となるバイオバンク・BRC(生物資源センター)等に関する有識者からなる「バイオテ
クノロジー産業戦略検討委員会」を設置し、バイオテクノロジー産業の健全かつ中長期的
な発展に向けた検討を重ね、平成28年1月14日に経済産業省に対し「バイオテクノロジー
産業の新たな発展に向けた政策提言書」を提出しました。
詳細につきましては下記HPをご覧ください。
【政策提言について】
https://www.nite.go.jp/nbrc/information/2016_bio_proposal.html
【プレスリリース】
https://www.nite.go.jp/nbrc/information/release/20160114.html
================================================================================
5.NITEバイオテクノロジーセンター展示のお知らせ
================================================================================
以下に出展いたします。お立ち寄りいただいた皆様からのご相談やご質問にもお答えし
ます。是非お越しください。
日本農芸化学会2016年度大会
日程:平成28年3月27日(日)~30日(水)
場所:札幌コンベンションセンター
(附設展示会会場)札幌産業振興センター・技能訓練棟2階(28日~30日)
http://www.jsbba.or.jp/2016/
================================================================================
編集後記
================================================================================
今冬は記録的な暖冬で始まりましたが、一月中旬頃から急に寒くなりました。先日は、
沖縄本島で観測史上初めて雪が降るほどの大寒波にも見舞われ、穏やかな冬は最初だけと
なってしまいました。調べてみると、今冬のような暖冬と言われる年の方が関東地方など
の太平洋側に大雪が降る可能性が高くなるそうです。一昨年、関東地方が記録的な大雪に
見舞われたことは記憶に新しいですが、その時私は出張先で動けなくなり、ひどい目に遭
いました。残りの冬は穏やかな気候が続くことを願うばかりです。(MH)
◆◇◆ ━━━━━━━━━━━━━━━━━━━━━━━━━━━━━━━━ ◆◇◆
・画像付きのバックナンバーを以下のサイトに掲載しております。受信アドレス変更、
受信停止も以下のサイトからお手続きいただけます。
https://www.nite.go.jp/nbrc/cultures/others/nbrcnews/nbrcnews.html
・NBRCニュースは配信登録いただいたメールアドレスにお送りしております。
万が一間違えて配信されておりましたら、お手数ですが、下記のアドレスにご連絡く
ださい。
・ご質問、転載のご要望など、NBRCニュースについてのお問い合わせは、下記のアドレ
スにご連絡ください。
・掲載内容は予告なく変更することがございます。掲載内容を許可なく複製・転載され
ることを禁止します。
・偶数月の1日(休日の場合はその前後)に配信します。第38号は2016年3月31日に配
信予定です。
編集・発行
独立行政法人製品評価技術基盤機構(NITE)バイオテクノロジーセンター
NBRCニュース編集局(nbrcnews@nite.go.jp)
◆◇◆ ━━━━━━━━━━━━━━━━━━━━━━━━━━━━━━━━ ◆◇◆
お問い合わせ
-
独立行政法人製品評価技術基盤機構 バイオテクノロジーセンター
生物資源利用促進課
(お問い合わせはできる限りお問い合わせフォームにてお願いします)
-
TEL:0438-20-5763
住所:〒292-0818 千葉県木更津市かずさ鎌足2-5-8 地図
お問い合わせフォームへ